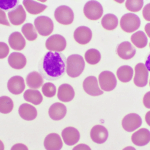
Joy Cancer Awareness Month: Expert warns parents on early signs and treatment of childhood leukaemia Joy Cancer Awareness Month: Expert warns parents on early signs and treatment of childhood leukaemia

A Paediatric Oncologist at the Korle-Bu Teaching Hospital, Dr Samira Yamyolia, has advised parents to pay close attention to unusual and persistent symptoms in their children, as these could signal the presence of Acute Lymphoblastic Leukaemia (ALL).
Speaking on the Joy FM Super Morning Show, on Wednesday, October 29, as part of Joy Cancer Awareness Month, Dr Yamyolia described the common warning signs of the disease, saying that early recognition could save a child’s life.
“One of the commonest signs is fever that lasts for a long time and does not respond to antibiotics or malaria treatment. Children may also bleed easily, sometimes from the gums or in the urine, or have small reddish spots under the skin indicating bleeding.”
She added that some children experience bone pain, which can appear in different parts of the body at different times.
“The pain may be in the leg today and the chest, tomorrow you may also notice that the child looks very pale because their haemoglobin levels are low.”
Other signs include swollen lymph nodes around the neck, behind the ears, or in the armpit, as well as an unusually enlarged abdomen due to swelling of the spleen or liver.
Dr Yamyolia noted that while some of these symptoms could occur in other conditions, persistent or unexplained cases should always be investigated by a medical professional.
“Sometimes a child may have a small cut that keeps bleeding for too long, or the amount of bleeding doesn’t match the size of the injury. Such things must be checked to rule out leukaemia.”
Dr Yamyolia said treatment for childhood leukaemia could last up to three years, starting with an intensive first year of chemotherapy followed by maintenance therapy.
“The mainstay of treatment is chemotherapy. We also do bone marrow transplants in some cases, but in Ghana, we mainly provide chemotherapy. Most children respond well to it.”
She acknowledged that chemotherapy comes with side effects, such as hair loss, nausea, and reduced immunity, but reassured parents that these are temporary.
“Hair loss is not permanent. By the time the child reaches the maintenance phase, the hair starts to grow back.”
During treatment, children are often advised to stay out of school to avoid infections, but many return once their therapy becomes less intensive.
“We even have NGOs that help the children at Korle-Bu,” she added. “There’s a hostel for families who travel from afar, and teachers come to the ward to help the children keep up with their studies.”
“There is help available. The good news is that ALL is curable, and children can recover completely with proper treatment,” she assured.